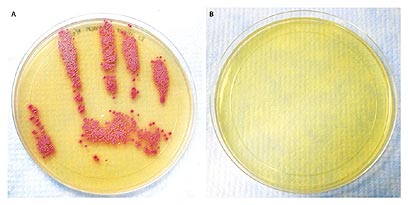

מה קרה בידיו של רופא לאחר שנגע במטופל?
רופא אמריקאי בדק מטופל שלא סבל מסימני זיהום, ואחר כך הטביע את כף ידו בצלוחית לגידול תרביות. תוך זמן קצר שיגשגה שם מושבה של חיידק מסוכן. המסקנה? רופאים חייבים לרחוץ ידיים ביסודיות אחרי כל בדיקה, גם אם מדובר בכאב גב
זה אולי נראה כמו ציור שהכין הילד בגן לאחר שטבל את ידיו בצבע, אבל מדובר בשיעור חשוב במניעת זיהומים בבתי חולים: בתמונה המדהימה הזו, שפורסמה לאחרונה בכתב העת הרפואי "ניו־אינגלנד ג'ורנל אוף מדיסין", נראות טביעות ידיו של רופא אמריקאי שנדבק ב־MRSA (סטאפילוקוק זהוב עמיד מתיצילין) - אחד החיידקים האלימים ביותר הידועים לאנושות. הדבר המפתיע הוא שהמטופל שממנו נדבק הרופא, לא סבל מתסמינים של זיהום או דלקת.
כדי להדגים עד כמה החיידק הזה מדבק גם כשמדובר באנשים ללא סימפטומים של מחלה, הטביע הרופא את כף ידו על צלחת פטרי (המשמשת לתרבית, שעליה צומחים חיידקים) לאחר שבדק חולה משותק בן 24. החולה לא סבל מכל תסמינים של זיהום או דלקת, אך דגימה מנחיריו הראתה כי הוא נושא את חיידק ה־MRSA. הרופא ערך לו בדיקה גופנית, לאחריה הטביע את כף ידו בצלחת, כמו זו המופיעה כאן בתמונה (מימין). לאחר הדגרה במעבדה, נדהמו הרופאים לגלות את חיידק ה־MRSA גדל במהירות על הצלחת (משמאל).
MRSA הוא זן של משפחת חיידקים שנקראת סטאפילוקוקוס. החיידק המקורי שממנו הוא צמח נקרא סטאפילוקוק אאוראוס והוא שוכן בדרך קבע על העור ובעיקר בנחיריים. בדרך כלל חיידקים ממשפחת הסטאפילוקוקוס אינם מזיקים, אלא כשהם חודרים לגוף דרך חתך, פצע פתוח, קטטרים המוחדרים לכלי הדם או לדרכי השתן, או שימוש במחטים מזוהמות. במקרים הללו גורם החיידק למחלות קשות ומסכנות חיים.
החיידק MRSA התגלה בשנת 1990, והתברר שהוא עמיד לרוב סוגי האנטיביוטיקה הקיימים כיום. אחת האנטיביוטיקות הבודדות שיכולות לגבור עליו היא ונקומיצין - אנטיביוטיקה רבת עוצמה, שגם היא לא תמיד מצליחה להתגבר עליו. ב־2007 גרם החיידק הזה, לפי הערכות, ל־94 אלף זיהומים מסכני חיים, שהביאו למותם של 18,650 אמריקאים. כמחצית מהחולים נדבקו מהחיידק בעת ששהו בבית חולים - בין אם אחרי ניתוח, ביחידות לטיפול נמרץ או ביחידות דיאליזה. שאר החולים נדבקו מחוץ לבית החולים.
כדי לעצור את התפשטות החיידק האלים קרא המרכז לבקרת מחלות בארה"ב להגביר את ההקפדה על היגיינה אישית ונטילת ידיים בבתי החולים, עובדים ומבקרים גם יחד, גם לאחר מגע עם חולים שלא נראה שהם נגועים בזיהום כלשהו. כן הדגישו מומחי המרכז את הצורך להפחית את השימוש באנטיביוטיקה שמגבירה את היווצרותם של זני חיידקים עמידים. זני החיידקים הנחשפים שוב ושוב לאנטיביוטיקה, גם שלא לצורך, משנים את המטען הגנטי שלהם בהתאם ויוצרים מושבות חיידקים חדשות שאינן פגיעות לתרופות האנטיביוטיות הסטנדרטיות.
ומה קורה אצלנו? ההערכה היא כי כ־4,000 מאושפזים מתים בישראל מדי שנה בעקבות זיהומים. ב־70% מהמקרים מדובר בחיידק MRSA שעמיד למתיצילין, VRE שעמיד לוונקומיצין, וקלבסיאלה שעמידה לכל סוגי האנטיביוטיקה. מומחים במשרד הבריאות סבורים שאפשר היה למנוע את מותם של כ־1,000 חולים בשנה, אילו היו נעשות מספיק פעולות למיגור תופעת הזיהומים.